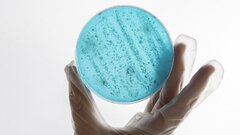

Ученые из Института органической химии имени Н.Д. Зелинского РАН разработали инновационный подход к анализу бактериальных биопленок, говорится на сайте Российской академии наук. Метод позволяет рассматривать их не как отдельные клетки, а как единую систему взаимодействий, а также открывает новые перспективы для создания эффективных антибактериальных материалов.
Биопленки — это сложные сообщества бактерий, формирующиеся на различных поверхностях. Они обладают высокой устойчивостью к антибиотикам и играют ключевую роль в развитии хронических инфекций и биозагрязнении. Традиционные методы анализа, как правило, изучают бактерии по отдельности, что не позволяет оценить их коллективное поведение и структуру.
Предложенный российскими учеными подход основан на представлении биопленки в виде графа — математической модели, где каждая бактерия — это «вершина», а взаимодействия между ними — «ребра». Для построения такой структуры были использованы методы электронной микроскопии и глубокого обучения. Сначала нейросеть Mask R-CNN выделяет отдельные клетки на изображении, а затем модель BINet определяет, взаимодействуют ли они между собой.
Новый метод позволяет выявлять скрытые закономерности в организации биопленок, которые невозможно обнаружить с помощью классических подходов. Например, по структуре графа можно определить стадию развития биопленки и даже тип поверхности, на которой она формируется. Это дает возможность прогнозировать рост бактериальных сообществ и оценивать эффективность антимикробных материалов.
«Мы предложили рассматривать биопленку как сеть взаимодействующих клеток, а не как набор отдельных бактерий. Это позволяет выявлять структурные закономерности и прогнозировать развитие системы, что ранее было недоступно», — комментирует руководитель исследования академик РАН Валентин Анаников.
Метод масштабируем и может быть адаптирован для различных типов микроорганизмов и поверхностей. В будущем его планируют дополнить химическими и генетическими данными, что позволит связать структуру биопленок с их функциями и устойчивостью. Таким образом, разработанный подход открывает новые возможности для создания антибактериальных материалов, контроля биозагрязнения и более эффективного лечения инфекций, связанных с биопленками.
Ранее Hi-Tech Mail рассказал, как мидии помогли ученым создать суперэффективный антибиотик.
Источник: hi-tech.mail.ru